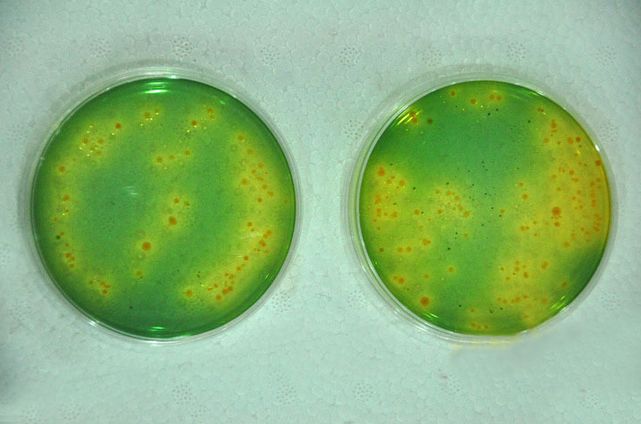

- д»ӘеҷЁ
- еҲҶжһҗд»ӘеҷЁ
- е®һйӘҢе®Өеёёз”Ёи®ҫеӨҶь/a>
- е…үеӯҰд»ӘеҷЁеҸҠи®ҫеӨҶь/a>
- зү©жҖ§жөӢиҜ•д»ӘеҷЁеҸҠи®ҫеӨҮ
- жөӢйҮҸ/и®ЎйҮҸд»ӘеҷЁ
- зҺҜеўғзӣ‘жөӢд»ӘеҷЁ
- з”ҹе‘Ҫ科еӯҰд»ӘеҷЁ/и®ҫеӨҮ
- иЎҢдёҡдё“з”Ёд»ӘеҷЁ
- е·ҘдёҡеңЁзәҝеҸҠиҝҮзЁӢжҺ§еҲ¶д»Әеҷ?/a>
- д»ӘеҷЁи®ҫеӨҮеҲ¶йҖҹь/a>
- й…Қ件гҖҒиҖ—жқҗдёҺжңҚеҠ ь/a>
- дј ж„ҹеҷ?/a>
- е·Ҙдёҡзі»з»ҹ
- иҝһжҺҘжҠҖжң?/a>
- е·Ҙдёҡз”өжәҗ
- IO-Link
- е®үе…ЁжҠҖжң?/a>
- жңәжў°и®ҫеӨҮ
- жіөйҳҖд»ӘеҷЁд»ӘиЎЁжҲҗеһӢи®ҫеӨҮдј иҙЁи®ҫеӨҮеҲ¶еҶ·и®ҫеӨҮеҺӢеҠӣе®№еҷЁжҲҗеҘ—и®ҫеӨҮзңҹз©әи®ҫеӨҮеҲ¶иҚҜи®ҫеӨҮеҢ…иЈ…и®ҫеӨҮзҺҜдҝқи®ҫеӨҮеӮЁиҝҗи®ҫеӨҮеҲҶзҰ»и®ҫеӨҮдј зғӯи®ҫеӨҮе№ІзҮҘжңәжў°ж··еҗҲи®ҫеӨҮиҫ“йҖҒи®ҫеӨҶь/a>иҫ…еҠ©и®ҫеӨҮзІүзўҺи®ҫеӨҮеҸҚеә”и®ҫеӨҮеЎ‘ж–ҷдё“з”Ёи®ҫеӨҮж¶Ӯж–ҷдё“з”Ёи®ҫеӨҮж©Ўиғ¶дё“з”Ёи®ҫеӨҮе…¶е®ғи®ҫеӨҮ
- еҸӮеұ•еҺӮе•Ҷ
- иө„и®Ҝ
- дё“йўҳ
- иө„ж–ҷ
- дјҡеұ•
- е“ҒзүҢ
- жӢӣиҒҳ
 m.cnreagent.com
m.cnreagent.com